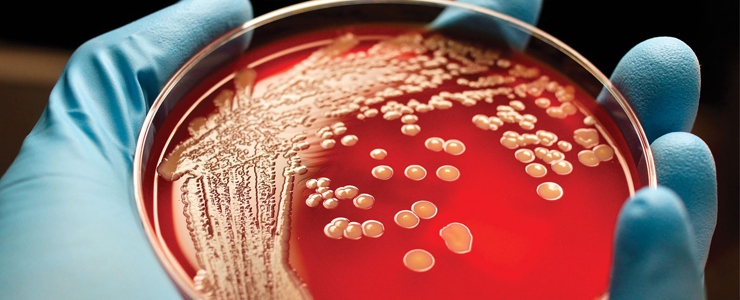

ISTITUTO
Archivio news ed eventi

18 dicembre 2018
Approccio One Health nella sorveglianza di zoonosi emergenti o riemergenti
Approccio One Health nella sorveglianza di zoonosi emergenti o riemergenti
17 dicembre 2018
Canili dinamici e nuove metodologie per la valutazione del benessere animale
Canili dinamici e nuove metodologie per la valutazione del benessere animale
14 dicembre 2018
Career Day UNITE 2018: studenti e laureati incontrano l'Istituto
Career Day UNITE 2018: studenti e laureati incontrano l'Istituto
12 dicembre 2018
Sospensione attività per chiusura invernale dell'Istituto
Sospensione attività per chiusura invernale dell'Istituto
12 dicembre 2018
L'Istituto in Sudafrica per rafforzare la partnership Italia-Africa
L'Istituto in Sudafrica per rafforzare la partnership Italia-Africa
11 dicembre 2018
The Role of Veterinary Services on Animal Welfare in natural disasters for Balkan countries
The Role of Veterinary Services on Animal Welfare in natural disasters for Balkan countries
10 dicembre 2018
La fatturazione elettronica obbligatoria da gennaio 2019
La fatturazione elettronica obbligatoria da gennaio 2019
06 dicembre 2018
Antimicrobicoresistenza: problemi attuali e impegno per il futuro
Antimicrobicoresistenza: problemi attuali e impegno per il futuro
05 dicembre 2018
Twinning OIE tra IZSAM e Università di Pretoria
Twinning OIE tra IZSAM e Università di Pretoria04 dicembre 2018
Percorso formativo sul protocollo Shelter Quality
Percorso formativo sul protocollo Shelter Quality
23 novembre 2018
Benessere animale, qualità e sicurezza microbiologica delle carni
Benessere animale, qualità e sicurezza microbiologica delle carni
21 novembre 2018
Benessere animale negli allevamenti di polli allevati per la produzione di carni
Benessere animale negli allevamenti di polli allevati per la produzione di carni
20 novembre 2018
L’Istituto al Congresso ISVEE15 di Chiang Mai
L’Istituto al Congresso ISVEE15 di Chiang Mai
19 novembre 2018
L'Istituto alla FAO per la gestione delle emergenze
L'Istituto alla FAO per la gestione delle emergenzeArchivio Comunicazione
Covid-19 l'impegno dell'IZS 5 x 1000 all'IZS Calendari IZS Archivio Newsletter I nostri video Museo del Gatto


